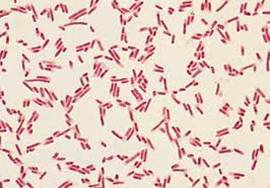

CARACTERISTICAS GENERALES.:
Citrobacter junto con Enterobacter, Klebsiella y Escherichia forma el grupo coliforme de bacterias entéricas.
Ø Son bacterias moviles,
Ø fermentadores variables de la lactosa,
algunos son citrato positivos y otros negativos.
HABITAD.:
Las bacterias entéricas son microorganismos que habitan, generalmente, en el intestino de los animales y las personas, pudiendo causar enfermedades en algunos casos.
Ø El tamaño promedio de los bacilos es de 0.5 micras de ancho por 3 micras de largo.
Ø Son catalasa positiva.
Ø Oxidasa negativos.
Ø Reducen nitratos a nitritos.
PATOGENESIDAD.:
Ø Las bacterias de este grupo pueden contaminar alimentos al inicio de producción del alimento. O durante su proceso de elaboración (alimentos contaminados por el manipulador de alimentos).
CARACTERISTICAS DEL GENERO DE ENTEROBACTERIAS.:
El capsular que es de naturaleza polisacarida conocida como antigeno «K»
El somatico tambien llamado antigeno «O» que de igual forma es un polisacarido. Y es parte del lipopolisacarido.
Antigeno flagelar ó «H» es de constitucion proteica.
EPIDEMIOLOGIA.:
Ademas tiene otros antigenos menores como proteinas de memebrana externa y fimbrias.
se encuentran frecuentemente en el agua, suelo, comida y el tracto intestinal de animales y humanos como flora saprófita.
ASPECTOS CLINICOS Y PRONOSIS.:_
Ø Que estos microorganismos pueden producir infecciones importantes, especialmente en huéspedes inmunodepresivos.
Ø Son organismos ubicuos y son causa frecuente de infecciones en el hombre, en especial infecciones urinarias, meningitis neonatal y abscesos cerebrales.
Ø Es uno de los patógenos más importantes en unidades de cuidados neonatales hospitalarios.
Ø Destruyen las microvellosidades, formando lesiones muy características denominadas de adherencia y eliminación.
PUBLICO.:_ LETICIA MONSERRAT ANTELE LOPEZ.
PUBLICO.:_ LETICIA MONSERRAT ANTELE LOPEZ.

Gracias!
ResponderEliminar